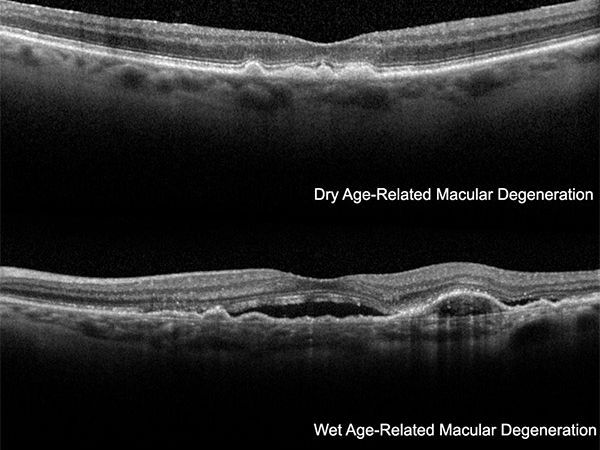

Vitreous Retina Macula Consultants of New York Clinic in New York, United States

Top Specialities:



Description
The ophthalmologists and retina specialists at Vitreous Retina Macula Consultants of New York are internationally known leaders in diagnosing and treating retinal diseases.
VRMNY retina doctors have trained and taught at some of the world`s finest and most respected academic institutions. The physicians who comprise the best retina specialists in New York are experts in vitrectomy surgery and hold academic appointments at Lenox Hill Hospital, New York University, and the New York Eye and Ear Infirmary.
Our ophthalmologists in New York City specialize in treating all medical and surgical retinal conditions, emphasizing macular degeneration and diabetic eye disease, the two leading causes of retinal vision loss.
With state-of-the-art New York ophthalmology centers in Manhattan, VRMNY is the largest retina vitreous center in the New York Metropolitan area.
Our New York ophthalmologists and eye doctors publish more in the foremost peer-reviewed journals than any other private or academic group in the United States. The practice devotes its time and resources to research and developing new diagnostic and therapeutic strategies. Many current concepts in retinal disease and treatment recognized worldwide were invented at VRMNY.
The attention, empathetic concern, and careful approach of the eye care specialists and their support team of retina surgeons explain the success of VRMNY. The over 60-member staff provides a full range of educational, medical, and surgical services. With an emphasis on patient education, the staff delivers compassionate and empowering care.
For more information about the Vitreous Retina Macula Consultants of New York, our doctors, or to schedule a consultation with Dr. Lawrence A. Yannuzzi, MD, please contact our ophthalmology practice by number: (212) 861-9797.
Vitreous Retina Macula Consultants of New York
950 3rd Ave 3rd floor,
New York, NY 10022
Office Tel # (212) 861-9797
Fax: (212) 628–0698
Web Address:
https://www.vrmny.com/
https://www.vrmny.com/locations/manhattan/
Our location on the map:
https://goo.gl/maps/v9rE1BWBd6tsFgPaA
https://plus.codes/87G8Q26J+3R New York
Nearby Locations:
Manhattan, NY
Lenox Hill | Upper East Side | Midtown East | Upper West Side
10021 | 10022 | 10023
Working Hours:
Monday-Friday: 8am–5pm
Payment: cash, check, credit cards.
Our Partners
Medical Tourism Insurance Companies:
Medical Tourism Travel Agencies:
Official URL
Our Websites
Spoken Languages

Reviews for Vitreous Retina Macula Consultants of New York
This medical office is one of the best I have ever been to. It is very clean, the staff provides all the information needed and respond to everything in a very timely manner. My appointments always start on time and I never had a single problem with them.